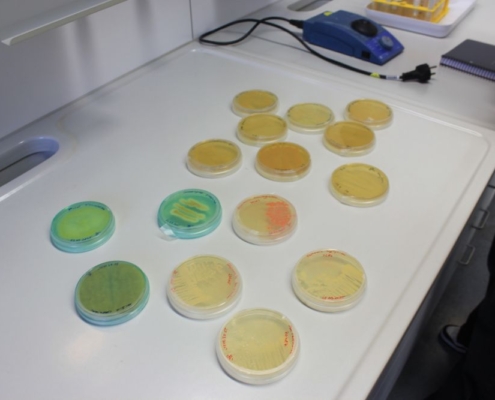

Kooperation erleichtert Schüler:innen den Übergang ins Studium und eröffnet neue Perspektiven
Am 9. Oktober 2025 besuchten die Mittel- und Oberstufen der Chemisch-technischen Assistent:innen (CTA) und Biologisch-technischen Assistent:innen (BTA) des Heinrich-Hertz-Berufskollegs (HHBK) mit ihren Klassenlehrer:innen den Fachbereich Chemie der Hochschule Niederrhein (HSNR) am Standort Krefeld-West. Insgesamt nahmen acht Klassen an dem Kooperationstag teil. Ziel war es, den Schüler:innen praxisnahe Einblicke in Forschung, Studium und Berufsperspektiven zu geben – und zugleich zu zeigen, wie eng das HHBK und die Hochschule zusammenarbeiten, um den Übergang von der Ausbildung ins Studium zu erleichtern.
Begrüßt wurden die Gruppen durch Prof. Dr. Martin Jäger, Dekan des Fachbereichs Chemie. Er bezeichnete den Tag als „einmalige Gelegenheit, Informationen aus erster Hand“ zu erhalten und lobte die Kooperation als gewinnbringend für beide Seiten.
Auch Bernie Dann von der Zentralen Studienberatung stellte die Studienangebote und Unterstützungsstrukturen der Hochschule vor. Sie wird am 11. Dezember 2025 auch am HHBK persönlich beraten – ein weiteres Zeichen für die enge Verzahnung von Schule und Hochschule.
Prof. Dr. Kerstin Hoffmann-Jacobsen informierte über den Bachelorstudiengang Chemie und machte Mut: Der Studiengang ist zulassungsfrei (kein NC), die Erfolgsquoten sind hoch, und ein dreiwöchiger Mathematik-Vorkurs erleichtert den Einstieg.
Die Hochschule unterhält enge Kontakte zu regionalen Chemieunternehmen, was viele Möglichkeiten für Praxissemester, Werkstudententätigkeiten oder Abschlussarbeiten in der Industrie eröffnet. Nach Bachelor und Master sind sogar kooperative Promotionen in Zusammenarbeit mit Universitäten, etwa der Universität Duisburg-Essen, möglich.
„Wer Interesse und Neugier mitbringt, findet hier alle Chancen für eine erfolgreiche Laufbahn – von der Ausbildung über das Studium bis hin zur Forschung,“ betonte Hoffmann-Jacobsen.
Im weiteren Verlauf der Veranstaltung informierten Birgit Klein, Beratungslehrerin am Heinrich-Hertz-Berufskolleg, und Prof. Dr. Martin Jäger vom Fachbereich Chemie der Hochschule Niederrhein über die bestehenden Kooperationsvereinbarungen zwischen beiden Einrichtungen. Dabei stellten sie auch die Anerkennung ausgewählter Unterrichts- und Laborleistungen aus den Bildungsgängen CTA und BTA vor, die den Übergang ins Studium an der Hochschule erleichtern:
| Kooperation HHBK – Hochschule Niederrhein, Fachbereich Chemie FB01 Chemie (HSNR) erkennt folgende Leistungen an: |
||||
|---|---|---|---|---|
| Lehrinhalte / Praktika | CTA (FHR) | CTA (AHR) | BTA (FHR) | BTA (AHR) |
| Organische Chemie (Praktikum – Testat) | X | X | • | • |
| Experimentelle Methoden der Chemie (Modul) | X | X | • | • |
| Mikrobiologie-Praktikum – Testat | – | – | X | X |
| Biochemie-Praktikum – Testat | – | |||
Anerkennung gemäß den an der Hochschule durchgeführten Inhalten (z. B. ELISA, Instrumentelle Analytik usw.)
Weitere Kooperationspunkte:
- Betriebspraktika
- Engineering Days
- Tag der offenen Tür
- Lange Nacht der Studienorientierung
Die Vorstellung dieser Regelung war für viele der anwesenden Schüler:innen besonders interessant, da sie konkret zeigt, wie Leistungen aus der schulischen Ausbildung auf ein späteres Studium angerechnet werden können. So wird die Verbindung zwischen beruflicher und akademischer Bildung greifbar – ein Beispiel dafür, wie die Kooperation praktisch funktioniert und echte Vorteile für HHBK-Schüler:innen bietet.
Einen Blick auf die gesellschaftliche Bedeutung der Chemie gab Prof. Dr.-Ing. Heyko Jürgen Schultz in seinem Vortrag „Chemie in der Industrie“. Er beschrieb die Chemie als interdisziplinäre Wissenschaft, die maßgeblich dazu beiträgt, Zukunftsfragen der Menschheit zu lösen.
„Wir befähigen Sie dazu, anwendungsorientiert in der Industrie Fuß zu fassen,“ so Schultz. Chemiker:innen seien, sagte er, Problemlöser:innen der Zukunft, die wertvolle Beiträge für Gesellschaft, Umwelt und Nachhaltigkeit leisten.
Er schloss mit den Worten:
„Ihr zukünftiger Beruf ist der schönste mögliche Zustand – eine spannende, erfüllende und bedeutende Aufgabe. Sie haben alles richtig gemacht, hier zu sein.“
Im Anschluss erhielten die Schüler:innen Einblicke in verschiedene Labore:
Im Lacklabor stand die Forschung rund um Bindemittel- und UV-Lacke im Mittelpunkt. Hier konnten die Schüler:innen beobachten, wie Lacke im Spritzraum aufgetragen und im Messraum mit spektroskopischen und elektrochemischen Verfahren untersucht werden. Auch die mechanischen Eigenschaften der Beschichtungen wurden geprüft – ein Beispiel für praxisnahe Materialforschung.
In diesem Labor trafen die Besucher:innen Daniel Sandvoß, einen ehemaligen HHBK-Schüler, der heute im Bereich Lacktechnik promoviert. Er berichtete, wie sehr ihm die Ausbildung am HHBK geholfen habe: „Das Know-how und die Sichtweisen aus meiner Ausbildung haben mir im Studium sehr geholfen,“ sagte er. Besonders die Praxisorientierung und Industrienähe der Hochschule Niederrhein habe er als wertvoll erlebt.
Das physikalisch-technische Labor bot Einblicke in angewandte Verfahren wie Chemietechnik, Kaffeeröstung und Abgasfilterung, bei denen chemische Prozesse mit technischer Anlagentechnik kombiniert werden.
Besonders großes Interesse weckten die biologischen und bioanalytischen Labore, in denen die Gruppen gentechnische und biotechnologische Verfahren kennenlernen konnten. Dazu gehörten unter anderem die Herstellung von Proteinen mithilfe von Mikroorganismen, die Arbeit mit Nährbodenansätzen und die Kultivierung von Zellkulturen.
Erläutert wurde außerdem, wie Enzyme als biologische Katalysatoren in der Industrie genutzt werden können – etwa beim Abbau von Kunststoffen oder in der Lebensmitteltechnologie.
Auch die Proteinherstellung in Schimmelpilzen und die Überwachung biotechnologischer Prozesse mittels bioanalytischer Methoden wurden demonstriert.
So erhielten die Schüler:innen einen anschaulichen Eindruck davon, wie moderne Gentechnik und Biotechnologie zur Lösung aktueller Umwelt- und Nachhaltigkeitsfragen beitragen.
„Am spannendsten waren die Labore, weil man sehen konnte, wie Forschung funktioniert,“ meinte eine Schülerin abschließend.
Nach den Laborführungen folgten noch zwei Fachvorträge:
Prof. Dr. Andreas Roppertz sprach über aktuelle Forschungen zur Katalyse im Umweltschutz, insbesondere zur Umsetzung von Luftschadstoffen durch heterogene Katalysatoren.
Anschließend stellte Prof. Dr. Jürgen Schram ein Projekt zur Analyse von Mikroplastik in Böden und Sedimenten vor, das bei den Teilnehmenden auf großes Interesse stieß.
„Das war richtig spannend, weil es direkt mit Umweltschutz zu tun hat,“ fasste ein Schüler seine Eindrücke zusammen.
Beim abschließenden Austausch bei Kaffee, Getränken und Gebäck nutzten Schüler:innen, Lehrkräfte und Dozierende die Gelegenheit zum Gespräch.
Die Veranstaltung machte deutlich, dass die Zusammenarbeit zwischen HHBK und Hochschule Niederrhein weit mehr als ein einmaliges Treffen ist:
Sie schafft greifbare Anschlussmöglichkeiten für naturwissenschaftlich interessierte Schüler:innen, bietet Anerkennung von Leistungen, Einblicke in Forschung und Industrie und unterstreicht, wie gut Praxis und Wissenschaft ineinandergreifen können.
Text: Sabine Fischer
Fotos: Robin Hochhausen